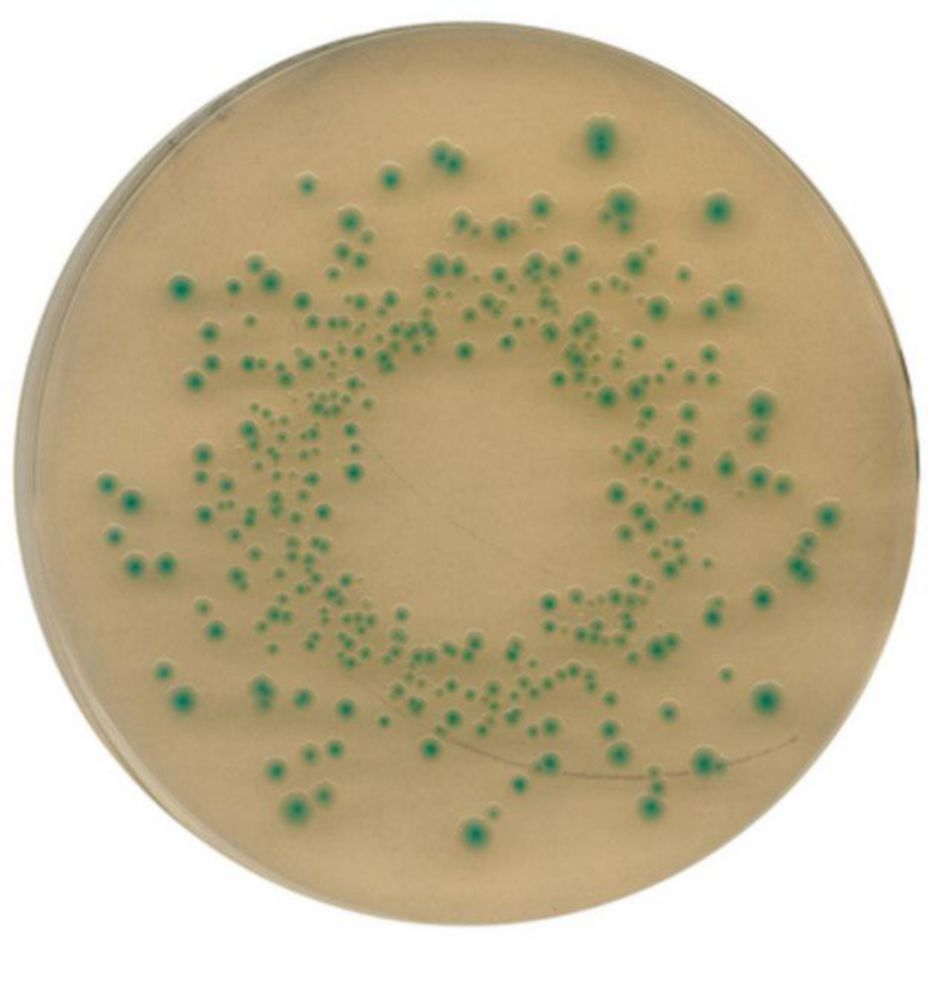
Chromcult TBX

SafetyCap I, V2.0, GL45, preperative, 1x PTFE-fitting 6,35mm OD+luchtventiel
Artikelnummer:
42307007

€ 101,40
Inhoud:
1ST
Levertijd: 5 werkdagen
Vragen over dit product?
🧑🔬 Al 130 jaar kennis en ervaring
⭐ Beoordeeld door klanten met een 7,9
👩💻 Persoonlijke aanpak met vaste contactpersonen
Productinformatie SafetyCap I, V2.0, GL45, preperative, 1x PTFE-fitting 6,35mm OD+luchtventiel
Eigenschappen